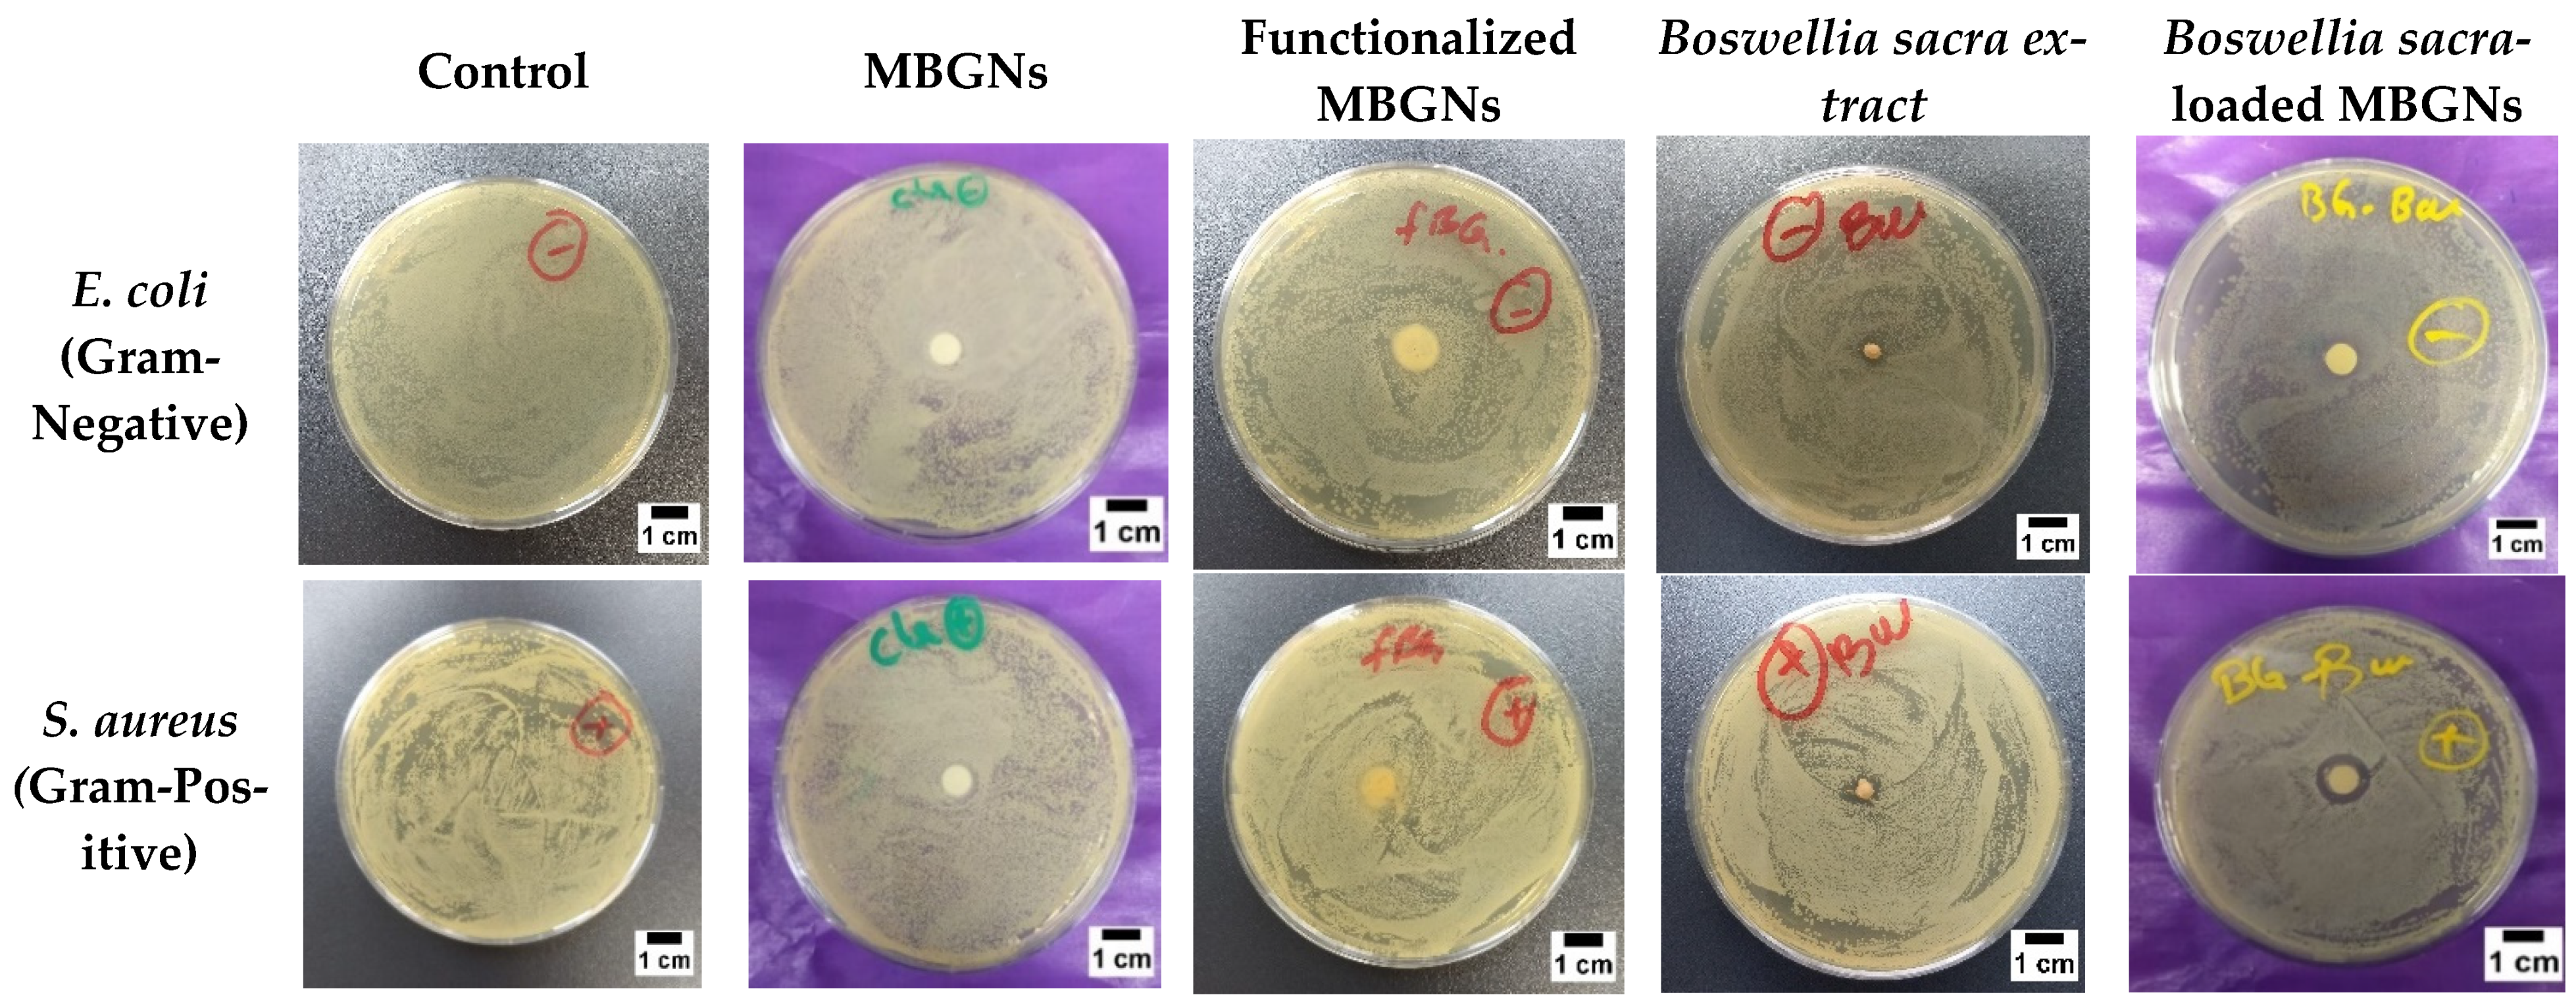
Pharmaceutics 14 00126 g007

Boswellia sacra Extract-Loaded Mesoporous Bioactive Glass Nano Particles: Synthesis and Biological Effects
Abstract
:1. Introduction
2. Materials and Methods
2.1. Synthesis of Mesoporous Bioactive Glass Nanoparticles
2.2. Plant Extraction Method
2.3. Surface Functionalization of Mbgns and Loading of Boswellia Sacra Extract
2.4. Characterization
2.4.1. Scanning Electron Microscopy
2.4.2. Structural and Chemical Analysis
2.4.3. In Vitro Release Studies
2.4.4. Antibacterial Characterization
2.4.5. In Vitro Cytocompatibility
2.5. Statistical Analysis
3. Results and Discussion
3.1. Morphological Analysis
3.2. Chemical Analysis
3.3. FTIR
3.4. XRD Analysis
3.5. Textural Properties
3.6. Zeta Potential
3.7. In Vitro Release Studies
3.8. Antibacterial Studies
3.9. Cytotoxicity Analysis
4. Conclusions
Author Contributions
Funding
Institutional Review Board Statement
Informed Consent Statement
Data Availability Statement
Acknowledgments
Conflicts of Interest
References
- Hench, L.L.; Splinter, R.J.; Allen, W.C.; Greenlee, T.K. Bonding mechanisms at the interface of ceramic prosthetic materials. J. Biomed. Mater. Res. 1971, 5, 117–141. [Google Scholar] [CrossRef]
- Xynos, I.D.; Hukkanen, M.; Batten, J.J.; Buttery, L.; Hench, L.L.; Polak, J.M. Bioglass® 45S5 Stimulates Osteoblast Turnover and Enhances Bone Formation In Vitro: Implications and Applications for Bone Tissue Engineering. Calcif. Tissue Int. 2000, 67, 321–329. [Google Scholar] [CrossRef]
- Hench, L.L.; Polak, J.M.; Xynos, I.D.; Buttery, L. Bioactive materials to control cell cycle. Mater. Res. Innov. 2000, 3, 313–323. [Google Scholar] [CrossRef]
- Wu, C.; Chang, J. Mesoporous bioactive glasses: Structure characteristics, drug/growth factor delivery and bone regeneration application. Interface Focus 2012, 2, 292–306. [Google Scholar] [CrossRef] [PubMed] [Green Version]
- Baino, F.; Hamzehlou, S.; Kargozar, S. Bioactive Glasses: Where Are We and Where Are We Going? J. Funct. Biomater. 2018, 9, 25. [Google Scholar] [CrossRef] [Green Version]
- Zheng, K.; Boccaccini, A.R. Sol-gel processing of bioactive glass nanoparticles: A review. Adv. Colloid Interface Sci. 2017, 249, 363–373. [Google Scholar] [CrossRef]
- Westhauser, F.; Wilkesmann, S.; Nawaz, Q.; Schmitz, S.I.; Moghaddam, A.; Boccaccini, A.R. Osteogenic properties of manganese-doped mesoporous bioactive glass nanoparticles. J. Biomed. Mater. Res. Part A 2020, 108, 1806–1815. [Google Scholar] [CrossRef] [Green Version]
- Zhang, X.; Zeng, D.; Li, N.; Wen, J.; Jiang, X.; Liu, C.; Li, Y. Functionalized mesoporous bioactive glass scaffolds for enhanced bone tissue regeneration. Sci. Rep. 2016, 6, srep19361. [Google Scholar] [CrossRef] [Green Version]
- Nawaz, Q.; Fuentes-Chandía, M.; Tharmalingam, V.; Rehman, M.A.U.; Leal-Egaña, A.; Boccaccini, A.R. Silibinin releasing mesoporous bioactive glass nanoparticles with potential for breast cancer therapy. Ceram. Int. 2020, 46, 29111–29119. [Google Scholar] [CrossRef]
- Schuhladen, K.; Roether, J.A.; Boccaccini, A.R. Bioactive glasses meet phytotherapeutics: The potential of natural herbal medicines to extend the functionality of bioactive glasses. Biomaterials 2019, 217, 119288. [Google Scholar] [CrossRef]
- Zheng, K.; Sui, B.; Ilyas, K.; Boccaccini, A.R. Porous bioactive glass micro- and nanospheres with controlled morphology: Developments, properties and emerging biomedical applications. Mater. Horiz. 2020, 8, 300–335. [Google Scholar] [CrossRef]
- Basch, E.; Boon, H.; Heerema, T.D.; Foppo, I.; Hashmi, S.; Hasskarl, J.; Sollars, D.; Ulbricht, C. Boswellia. J. Herb. Pharmacother. 2004, 4, 63–83. [Google Scholar] [CrossRef]
- Siddiqui, M.Z. Boswellia Serrata, A potential antiinflammatory agent: An overview. Indian J. Pharm. Sci. 2011, 73, 255–261. [Google Scholar] [CrossRef]
- Mertens, M.; Buettner, A.; Kirchhoff, E. The volatile constituents of frankincense—A review. Flavour Fragr. J. 2009, 24, 279–300. [Google Scholar] [CrossRef]
- Grbić, M.L.; Unković, N.; Dimkić, I.; Janaćković, P.; Gavrilović, M.; Stanojevic, O.; Stupar, M.; Vujisić, L.; Jelikić, A.; Stanković, S.; et al. Frankincense and myrrh essential oils and burn incense fume against micro-inhabitants of sacral ambients. Wisdom of the ancients? J. Ethnopharmacol. 2018, 219, 1–14. [Google Scholar] [CrossRef]
- Camarda, L.; Dayton, T.; Di Stefano, V.; Pitonzo, R.; Schillaci, D. Chemical composition and antimicrobial activity of some oleogum resin essential oils from Boswellia SPP. (Burseraceae). Ann. Di Chim. 2007, 97, 837–844. [Google Scholar] [CrossRef] [PubMed]
- Shah, A.T.; Batool, M.; Chaudhry, A.A.; Iqbal, F.; Javaid, A.; Zahid, S.; Ilyas, K.; bin Qasim, S.; Khan, A.F.; Khan, A.S.; et al. Effect of calcium hydroxide on mechanical strength and biological properties of bioactive glass. J. Mech. Behav. Biomed. Mater. 2016, 61, 617–626. [Google Scholar] [CrossRef] [PubMed]
- Hum, J.; Boccaccini, A.R. Collagen as Coating Material for 45S5 Bioactive Glass-Based Scaffolds for Bone Tissue Engineering. Int. J. Mol. Sci. 2018, 19, 1807. [Google Scholar] [CrossRef] [Green Version]
- Esmaeili, A.; Pourkhodabakhshi, F. Loading Metformin/Nettle Extract Lamium album L. subsp. Crinitum in Porous Hollow Silica Nanoparticle Coated by the Layer-by-Layer Method. Silicon 2020, 12, 521–534. [Google Scholar] [CrossRef]
- Santana, P.; Miranda, M.; Payrol, J.; Silva, M.; Rob, H. Gas Chromatography-Mass Spectrometry Study from the Leaves Fractions Obtained of Vernonanthura Patens (Kunth). 2013. Available online: https://www.scirp.org/html/1-1020186_32968.htm (accessed on 1 December 2021).
- Neščáková, Z.; Zheng, K.; Liverani, L.; Nawaz, Q.; Galusková, D.; Kaňková, H.; Michálek, M.; Galusek, D.; Boccaccini, A.R. Multifunctional zinc ion doped sol-gel derived mesoporous bioactive glass nanoparticles for biomedical applications. Bioact. Mater. 2019, 4, 312–321. [Google Scholar] [CrossRef]
- Bogush, G.; Tracy, M.; Zukoski, C. Preparation of monodisperse silica particles: Control of size and mass fraction. J. Non-Cryst. Solids 1988, 104, 95–106. [Google Scholar] [CrossRef]
- El-Kady, A.M.; Ahmed, M.M.; El-Hady, B.M.A.; Ali, A.F.; Ibrahim, A.M. Optimization of ciprofloxacin release kinetics of novel Nano-bioactive glasses: Effect of glass modifier content on drug loading and release mechanism. J. Non-Cryst. Solids 2019, 521, 119471. [Google Scholar] [CrossRef]
- MacKenzie, K.J.D.; Smith, M.E. Multinuclear Solid-State Nuclear Magnetic Resonance of Inorganic Materials; Elsevier: Amsterdam, The Netherlands, 2002. [Google Scholar]
- Kargozar, S.; Kermani, F.; Beidokhti, S.M.; Hamzehlou, S.; Verné, E.; Ferraris, S.; Baino, F. Functionalization and Surface Modifications of Bioactive Glasses (BGs): Tailoring of the Biological Response Working on the Outermost Surface Layer. Materials 2019, 12, 3696. [Google Scholar] [CrossRef] [PubMed] [Green Version]
- Guimarães, A.C.; Meireles, L.M.; Lemos, M.F.; Guimarães, M.C.C.; Endringer, D.C.; Fronza, M.; Scherer, R. Antibacterial activity of terpenes and terpenoids present in essential oils. Molecules 2019, 24, 2471. [Google Scholar] [CrossRef] [Green Version]
- Leal, L.; Ferreira, A.; Bezerra, G.; Matos, F.J. Antinociceptive, Anti-Inflammatory and Bronchodilator Activities of Brazilian Medicinal Plants Containing Coumarin: A Comparative Study, Elsevier. (n.d.). Available online: https://www.sciencedirect.com/science/article/pii/S0378874199001658?casa_token=J0JuaIRy8cQAAAAA:cT6NhaouhTUhCvyAN13hS--IAQkCprsVxbtIp_ky8jn2CaFVdjjfK0jhW2JBq2ueHsv3G6QZU3E (accessed on 1 December 2021).
- Sun, X.; Yang, X.; Xue, P.; Zhang, Z.; Ren, G. Improved antibacterial effects of alkali-transformed saponin from quinoa husks against halitosis-related bacteria. BMC Complement. Altern. Med. 2019, 19, 1–10. [Google Scholar] [CrossRef]
- Liu, Y.; McKeever, L.C.; Malik, N.S.A. Assessment of the antimicrobial activity of olive leaf extract against foodborne bacterial pathogens. Front. Microbiol. 2017, 8, 113. [Google Scholar] [CrossRef] [PubMed] [Green Version]
- Esmaeilzadeh, J.; Hesaraki, S.; Hadavi, S.M.-M.; Ebrahimzadeh, M.H.; Esfandeh, M. Poly (d/l) lactide/polycaprolactone/bioactive glasss nanocomposites materials for anterior cruciate ligament reconstruction screws: The effect of glass surface functionalization on mechanical properties and cell behaviors. Mater. Sci. Eng. C 2017, 77, 978–989. [Google Scholar] [CrossRef] [PubMed]
- Jiang, S.; Zhang, Y.; Shu, Y.; Wu, Z.; Cao, W.; Huang, W. Amino-functionalized mesoporous bioactive glass for drug delivery. Biomed. Mater. 2017, 12, 025017. [Google Scholar] [CrossRef]
- Fatimah, A.-O.; Alharbi, R.I.; Albasher, G.; Almeer, R.; Alsaggabi, N.S. Antifungal Potential of Aqueous Extract of Boswellia carteri. J. Pure Appl. Microbiol. 2019, 13, 2375–2381. [Google Scholar] [CrossRef] [Green Version]
- Zarghami, V.; Ghorbani, M.; Bagheri, K.P.; Shokrgozar, M.A. In vitro bactericidal and drug release properties of vancomycin-amino surface functionalized bioactive glass nanoparticles. Mater. Chem. Phys. 2020, 241, 122423. [Google Scholar] [CrossRef]
- Zhang, Y.; Luan, J.; Jiang, S.; Zhou, X.; Li, M. The effect of amino-functionalized mesoporous bioactive glass on MC3T3-E1 cells in vitro stimulation. Compos. Part Eng. 2019, 172, 397–405. [Google Scholar] [CrossRef]
- Lee, J.-H.; Kang, M.-S.; Mahapatra, C.; Kim, H.-W. Effect of aminated mesoporous bioactive glass nanoparticles on the differentiation of dental pulp stem cells. PLoS ONE 2016, 11, e0150727. [Google Scholar] [CrossRef] [Green Version]
- Kaasalainen, M.; Mäkilä, E.; Riikonen, J.; Kovalainen, M.; Järvinen, K.; Herzig, K.-H.; Lehto, V.-P.; Salonen, J. Effect of isotonic solutions and peptide adsorption on zeta potential of porous silicon nanoparticle drug delivery formulations. Int. J. Pharm. 2012, 431, 230–236. [Google Scholar] [CrossRef]
- Negut, I.; Floroian, L.; Ristoscu, C.; Mihailescu, C.N.; Rosca, J.C.M.; Tozar, T.; Badea, M.; Grumezescu, V.; Hapenciuc, C.; Mihailescu, I.N. Functional Bioglass—Biopolymer Double Nanostructure for Natural Antimicrobial Drug Extracts Delivery. Nanomaterials 2020, 10, 385. [Google Scholar] [CrossRef] [Green Version]
- Zhu, M.; Zhang, L.; He, Q.; Zhao, J.; Limin, G.; Shi, J. Mesoporous bioactive glass-coated poly(l-lactic acid) scaffolds: A sustained antibiotic drug release system for bone repairing. J. Mater. Chem. 2011, 21, 1064–1072. [Google Scholar] [CrossRef]
- Mothana, R.A.; Lindequist, U. Antimicrobial activity of some medicinal plants of the island Soqotra. J. Ethnopharmacol. 2005, 96, 177–181. [Google Scholar] [CrossRef] [PubMed]
- Hasson, S.; Al-Balushi, M.; Sallam, T.; Idris, M.; Habbal, O.; Al-Jabri, A. In vitro antibacterial activity of three medicinal plants-Boswellia (Luban) species. Asian Pac. J. Trop. Biomed. 2011, 1, S178–S182. [Google Scholar] [CrossRef]
- Al-Kuraishy, H.M.; Al-Gareeb, A.I.; Ashoor, A.W.; Al-Windy, S.A. Modifying effects of boswellia carteri on clarithromycine action: In vitro antibacterial study against common sensitive bacterial strains. Int. J. Drug. Dev. Res. 2012, 4, 155–162. [Google Scholar]
- Mahizan, N.A.; Yang, S.K.; Moo, C.L.; Song, A.A.L.; Chong, C.M.; Chong, C.W.; Abushelaibi, A.; Erin Lim, S.H.; Lai, K.S. Terpene Derivatives as a Potential Agent against Antimicrobial Resistance (AMR) Pathogens. Molecules 2019, 24, 2631. [Google Scholar] [CrossRef] [Green Version]
- Bai, F.; Chen, X.; Yang, H.; Xu, H.-G. Acetyl-11-Keto-β-Boswellic Acid Promotes Osteoblast Differentiation by Inhibiting Tumor Necrosis Factor-α and Nuclear Factor-κB Activity. J. Craniofac. Surg. 2018, 29, 1996–2002. [Google Scholar] [CrossRef] [PubMed]
- Takada, Y.; Ichikawa, H.; Badmaev, V.; Aggarwal, B.B. Acetyl-11-Keto-β-Boswellic Acid Potentiates Apoptosis, Inhibits Invasion, and Abolishes Osteoclastogenesis by Suppressing NF-κB and NF-κB-Regulated Gene Expression. J. Immunol. 2006, 176, 3127–3140. [Google Scholar] [CrossRef] [PubMed] [Green Version]

| Retention Time (Min) | Compounds | % Area | |
|---|---|---|---|
| 1 | 4.633 | α-Pinene | 36.96 |
| 2 | 5.092 | 7-Methoxy-3-(4-methoxyphenyl)coumarin | 1.81 |
| 3 | 5.724 | Limonene | 4.92 |
| 4 | 6.741 | Myrtenol | 0.45 |
| 5 | 6.999 | 5,7-Dihydroxy-4-methylcoumarin | 1.34 |
| 6 | 7.364 | α-Thujenal | 0.51 |
| 7 | 7.581 | p-Cymen-7-ol | 0.89 |
| 8 | 8.184 | Bornyl acetate | 0.41 |
| 9 | 8.93 | α-Terpineol | 0.37 |
| 10 | 9.25 | α-Selinene | 0.42 |
| 11 | 9.406 | δ-Guaiene | 1.39 |
| 12 | 9.673 | Caryophyllene | 0.51 |
| 13 | 9.964 | Humulene | 0.49 |
| 14 | 10.099 | Longifolene | 0.47 |
| 15 | 10.23 | γ-Gurjunene | 1.59 |
| 16 | 10.468 | Epicubebol | 0.66 |
| 17 | 10.956 | cis-Sesquisabinene hydrate | 0.53 |
| 18 | 11.161 | Farnesol | 0.67 |
| 19 | 11.342 | Himbaccol | 0.66 |
| 20 | 11.506 | α-Cadinol | 0.97 |
| 21 | 11.891 | (-)-Spathulenol | 0.48 |
| 22 | 12.621 | Thunbergene | 0.41 |
| 23 | 13.441 | β-Santalol | 0.50 |
| 24 | 13.667 | Lanceol, cis | 0.52 |
| 25 | 13.691 | β-Elemen | 0.77 |
| 26 | 13.888 | α-Terpinyl acetate | 0.67 |
| 27 | 13.966 | 3,6,3′,4′-Tetrahydroxyflavone | 0.63 |
| 28 | 14.249 | β Carotene | 3.12 |
| 29 | 14.512 | Kaur-16-ene | 0.97 |
| 30 | 14.815 | Squalene | 3.66 |
| 31 | 14.922 | Ledol | 13,22 |
| 32 | 15.11 | 7,3′,4′,5′-Tetramethoxyflavanone | 0.59 |
| 33 | 15.398 | Quercetin 3′-methyl ether | 0.52 |
| 34 | 16.414 | Ledene | 12.46 |
| 35 | 17.657 | Apigenin 8-C-glucoside | 0.42 |
| 36 | 18.006 | 2′-Hydroxy-2,4,4′,5-tetramethoxychalcone | 0.48 |
| 37 | 18.309 | Juniperol | 0.68 |
| 38 | 18.752 | Isovitexin | 0.51 |
| 39 | 19.814 | 6,2′,3′-Trimethoxyflavone | 0.54 |
| 40 | 20.118 | (-)-Globulol | 0.50 |
| 41 | 21.315 | 3-(3,4-Dimethoxyphenyl)-7-hydroxy-4-phenylcoumarin | 0.83 |
| 42 | 22.546 | 7-Hydroxychromanone | 0.75 |
| 43 | 22.878 | 4-Hydroxy-7-methoxy-3-(4-methoxyphenyl)coumarin | 0.77 |
| Type of BG | Pore Size (nm) | Pore Volume (cm3 g−1) | BET Surface Area (m2/g) |
|---|---|---|---|
| MBGNs | 2.02 | 0.2 | 100.5 |
| Functionalized MBGNs | 5.69 | 0.29 | 111.2 |
| Samples | Zeta Potential (mV) | Std. Dev. |
|---|---|---|
| MBGNs | −21.7 | ±0.8 |
| Functionalized MBGNs | −11.8 | ±0.2 |
| Boswellia sacra-loaded MBGNs | −32.2 | ±1.0 |
| Equation | Q = Kt(1/2) | |
|---|---|---|
| Functionalized MBGNs | K | 32.61819 |
| R2 | 0.99347 | |
| MBGNs | K | 51.77643 |
| R2 | 0.99989 | |
Publisher’s Note: MDPI stays neutral with regard to jurisdictional claims in published maps and institutional affiliations. |
© 2022 by the authors. Licensee MDPI, Basel, Switzerland. This article is an open access article distributed under the terms and conditions of the Creative Commons Attribution (CC BY) license (https://creativecommons.org/licenses/by/4.0/).
Share and Cite
Ilyas, K.; Singer, L.; Akhtar, M.A.; Bourauel, C.P.; Boccaccini, A.R. Boswellia sacra Extract-Loaded Mesoporous Bioactive Glass Nano Particles: Synthesis and Biological Effects. Pharmaceutics 2022, 14, 126. https://doi.org/10.3390/pharmaceutics14010126
Ilyas K, Singer L, Akhtar MA, Bourauel CP, Boccaccini AR. Boswellia sacra Extract-Loaded Mesoporous Bioactive Glass Nano Particles: Synthesis and Biological Effects. Pharmaceutics. 2022; 14(1):126. https://doi.org/10.3390/pharmaceutics14010126
Chicago/Turabian StyleIlyas, Kanwal, Lamia Singer, Muhammad Asim Akhtar, Christoph P. Bourauel, and Aldo R. Boccaccini. 2022. "Boswellia sacra Extract-Loaded Mesoporous Bioactive Glass Nano Particles: Synthesis and Biological Effects" Pharmaceutics 14, no. 1: 126. https://doi.org/10.3390/pharmaceutics14010126






